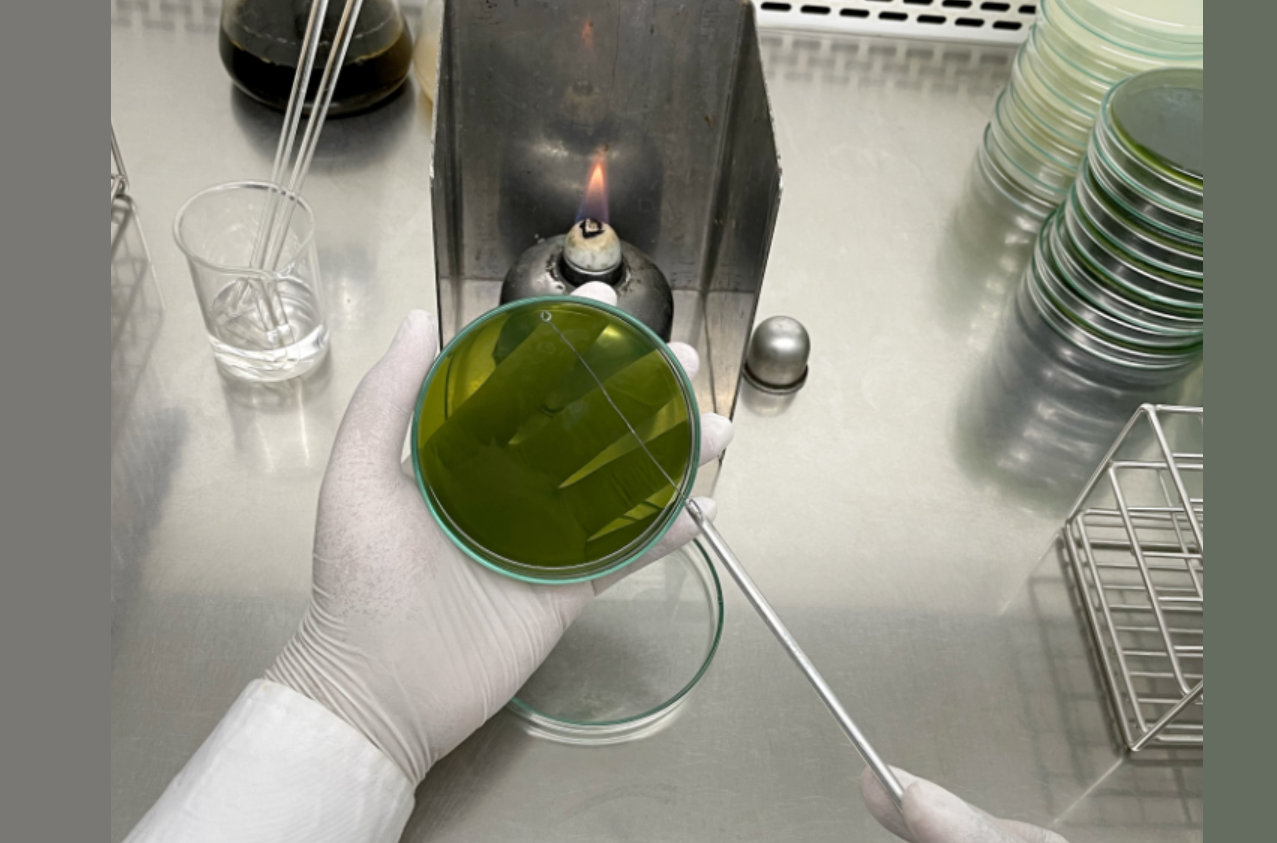
research-01
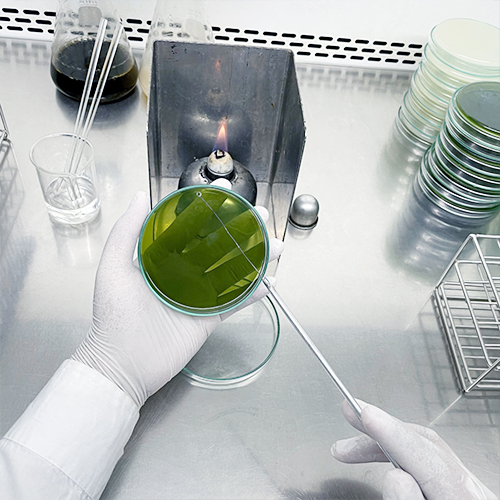
L6
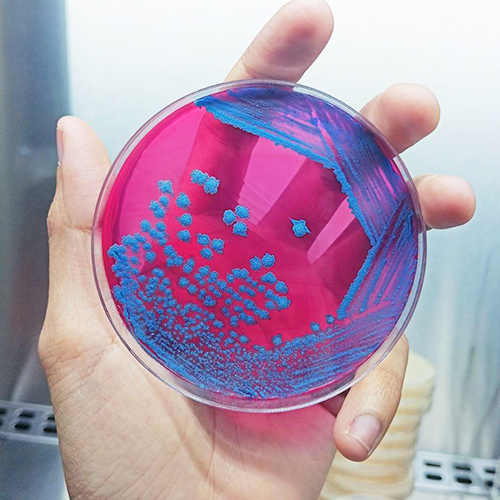
L7

โปร ไบโอเทค ฟีด
ขอแนะนำคุณค่าทางอาหาร สำหรับใช้ในสูตรอาหารสัตว์ เช่น สุกร สัตว์ปีก สัตว์เคี้ยวเอื้อง สัตว์น้ำ และสัตว์เลี้ยง

สุกร

สัตว์ปีก

สัตว์เคี้ยวเอื้อง

สัตว์น้ำ

กุ้ง

สัตว์เลี้ยง
Top Products
จำหน่ายผลิตภัณฑ์ถั่วเหลืองหมักคุณภาพสูง สามารถนำไปใช้ทดแทนแหล่งโปรตีนจากสัตว์

BIO-BOME
ผลิตภัณฑ์กากถั่วเหลืองหมักด้วยจุลินทรียกลุ่ม Lactobacillus spp. ร่วมกับยีสต์ Saccharomyces cerevisiae จุลินทรีย์ที่ใช้ในกระบวนหมัก สำหรับใช้ในสูตรอาหารสัตว์ ไม่ว่าจะเป็น สุกร สัตว์ปีก สัตว์เคี้ยวเอื้อง สัตว์น้ำ และสัตว์เลี้ยง

PRO-SB
ผลิตภัณฑ์กากถั่วเหลืองหมักด้วยจุลินทรีย์กลุ่ม Lactobacillus spp. ร่วมกับยีสต์ Saccharomyces cerevisiae พร้อมสารเสริมชีวนะจุลินทรีย์โปรไบโอติก Bacillus subtilis ที่มีคุณสมบัติช่วยย่อยสารอินทรีย์ตกค้างในระบบย่อยอาหารของสัตว์

PRO G MAX
อาหารเสริมชีวนะพร้อมโปรตีนย่อยง่าย สำหรับสัตว์ผลิตจากกากถั่วเหลืองคุณภาพสูง ที่ผ่านกระบวนการหมักด้วยวิธีธรรมชาติ สามารถนำ PRO G MAX ไปใช้ทดแทนโปรตีนเข้มข้น (Soy protein concentrate) หรือร่วมกับปลาป่น (Fish meal) ในสูตรอาหารได้
“โปร ไบโอเทค”
ให้ความสำคัญเกี่ยวกับการปรับปรุง และพัฒนาคุณภาพของผลิตภัณฑ์ถั่วหมักให้ดียิ่งขึ้นมาโดยตลอด จึงได้จัดตั้งหน่วยวิจัย และพัฒนาผลิตภัณฑ์ ตลอดจนพัฒนากระบวนการผลิต ให้สามารถผลิตผลิตภัณฑ์ถั่วเหลืองหมักคุณภาพสูง ได้ในระดับอุตสาหกรรม
โปร ไบโอเทค Quality Come First & Food safety
Product Research and Development
การวิจัยและพัฒนาผลิตภัณฑ์
บริษัท โปร ไบโอเทค ฟีด จำกัด
หรือเรียกพวกเราว่า “โปร ไบโอเทค”
ดำเนินการผลิตกากถั่วเหลืองหมักชีวภาพ (Fermented Soybean Meal Product) มาตั้งแต่ปีพ.ศ 2549 ที่จังหวัดสมุทรสาคร โดยเน้นการวิจัย และพัฒนาผลิตภัณฑ์ ให้มีคุณภาพมาเป็นอันดับแรก ตามนโยบายของบริษัท “Quality Come First” เพราะพวกเราโปร ไบโอเทค เชื่อว่าการตั้งต้นวัตถุดิบอาหารสัตว์ที่ดี จะมีผลต่อผลผลิตของคู่ค้า และยังเป็นประโยชน์กับผู้บริโภค ตามห่วงโซ่อาหาร ของระบบ “Food safety”

การวิจัยและพัฒนาผลิตภัณฑ์
(Product Research and Development)
บริษัทให้ความสำคัญเกี่ยวกับการปรับปรุงและพัฒนาคุณภาพของผลิตภัณฑ์ถั่วหมักให้ดียิ่งขึ้นมาโดยตลอด จึงได้จัดตั้งหน่วยวิจัย และพัฒนาผลิตภัณฑ์ขึ้นมา โดยมีดร. วิเชียร ยงมานิตชัย เป็นที่ปรึกษาอาวุโสในการดำเนินงานร่วมกับทีมงานวิจัย เริ่มจากโครงการคัดแยกจุลินทรีย์สายพันธุ์ของไทย ที่มีคุณสมบัติที่สำคัญอันดับแรก คือความปลอดภัยต่อสัตว์เลี้ยงในการบริโภค สามารถเจริญได้อย่างรวดเร็ว ผลิตเอนไซม์ปริมาณสูง ทำการคัดเลือกและนำไปทดสอบในกระบวนการหมัก พัฒนากระบวนการผลิต ให้สามารถผลิตผลิตภัณฑ์ถั่วเหลืองหมักคุณภาพสูงได้ในระดับอุตสาหกรรม เป็นผลิตภัณฑ์กากถั่วเหลืองที่ผ่านการหมักด้วยจุลินทรีย์กลุ่ม Lactic acid bacteria ยีสต์ และเพิ่ม Bacillus spp. เพื่อให้จุลินทรีย์เหล่านี้ทำงานร่วมกันอย่างมีประสิทธิภาพสูงสุด จนได้เป็นผลิตภัณฑ์กากถั่วเหลืองหมักที่มีคุณลักษณะตามความต้องการของอุตสาหกรรมอาหารสัตว์ เช่น มีปริมาณกรดแลคติกสูง ขนาดโมเลกุลโปรตีนเป็นเปปไทด์สายสั้น โปรตีนละลายน้ำได้ดีขึ้น ค่าการย่อยเปปซิน (Pepsin digestibility) ดีขึ้น และกำจัดหรือลดปริมาณสารต้านโภชนะในกากถั่วเหลือง (Trypsin inhibitor, Lectin, Oligosaccharides และ β-conglycinin) สามารถนำไปใช้ทดแทนแหล่งโปรตีนจากสัตว์ เช่น ปลาป่นได้
Request For Service
ที่อยู่ติดต่อ
บริษัท โปร ไบโอเทค ฟีด จำกัด เลขที่ 91/1 หมู่ 1 ต.นาโคก อ.เมือง จ.สมุทรสาคร 74000
Probiotechfeed Co.,Ltd. 91/1 Moo 1, Tambon Nakhok, Amphur Muang, Samutsakhon, 74000, Thailand.
เบอร์ติดต่อ
โทร. (034) 406574 โทรสาร. (034) 406575
TEL. +66 (34) 406 574 FAX. +66 (34) 406 575
อีเมล์
probiotechfeed@probiotechfeed.com